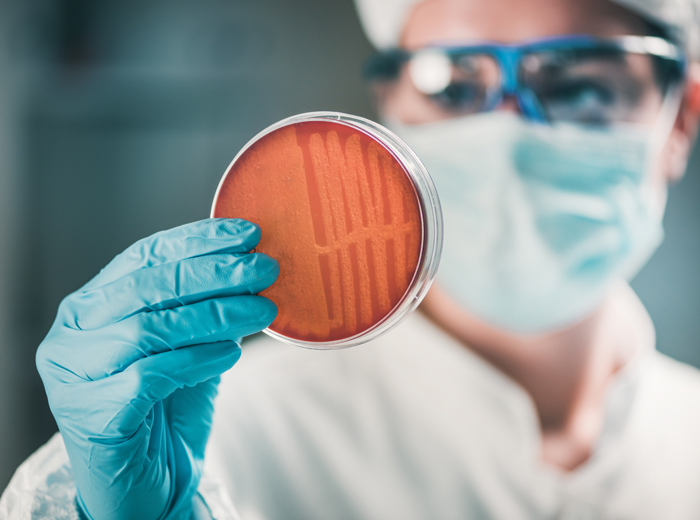

Month: November 2023
THAI SPICE
Supplier Finder November 2023
Alliance Technology Co., Ltd
We have been only official distributer of LOMA System in Thailand. We represent, Metal Detector, Checkweigher, X-Ray inspection use in the food and pharmaceutical industries. We are also a distributor of detectable products under the brand PROHACCP from Proland. There are devices use in food production lines according to the HACCP system. We also have a team of highly experienced engineers to provide a full range of services, whether installation Production line design, maintenance, spare parts and quality after-sales service.
บริษัท แอ็ลไลแอ็นซ์ เทคโนโลยี จำกัด
ตัวแทนจำหน่ายสินค้าภายใต้แบรนด์ LOMA จากประเทศอังกฤษ ซึ่งประกอบไปด้วย เครื่องตรวจจับโลหะ เครื่องชั่งน้ำหนักแบบระบบสายพาน และเครื่องเอ็กซเรย์ตรวจสอบสิ่งปลอมปน ที่ใช้ในอุตสาหกรรมอาหารและยา นอกจากนั้นเรายังเป็นตัวแทนจำหน่าย Detectable Product ภายใต้แบรนด์ PROHACCP จากประเทศโปรแลนด์ เป็นอุปกรณ์ที่ใช้ในไลน์การผลิตอาหารตามระบบ HACCP พร้อมทั้งเรายังมีทีมวิศวกรที่มีประสบการณ์สูงให้บริการแบบครบวงจรไม่ว่าจะเป็นงานติดตั้ง งานออกแบบไลน์การผลิต งานซ่อมบำรุง อะไหล่ และบริการหลังการขาย ที่มีคุณภาพ
ALS Laboratory Group (Thailand) Co., Ltd.
“ALS, A global leader in testing provided comprehensive testing solutions to clients in a wide range of industries all over the world. Our adoption of state-of-the-art technology and innovative methodologies – coupled with the strength of our international teams – ensure that we deliver the highest quality services.
ALS Thailand, An ISO/IEC 17025 accredited laboratory provides food, pharma, and environmental testing services with 8 locations in most major areas in Thailand, contact us at 09-1774-4329.”
เอแอลเอส แลบอราทอรี กรุ๊ป (ประเทศไทย) จำกัด
“ALS ผู้นำทางด้านการวิเคราะห์ระดับโลก ให้บริการครอบคลุมในหลากหลายกลุ่มอุตสาหกรรมทั่วโลก เรานำเทคโนโลยีและนวัตกรรมที่ทันสมัยมาใช้ พร้อมด้วยเครือข่ายผู้เชี่ยวชาญทั่วทุกมุมโลก ทำให้เรามั่นใจได้ว่าสามารถส่งมอบบริการที่มีคุณภาพและตรงตามความต้องการให้กับลูกค้าทุกท่าน
ALS ประเทศไทย ห้องปฏิบัติการวิเคราะห์ภายใต้การรับรอง ISO/IEC 17025 พร้อมให้บริการตรวจวิเคราะห์ตัวอย่างอาหาร ยา เวชภัณฑ์ และสิ่งแวดล้อม ด้วยศูนย์บริการ 8 แห่ง (กรุงเทพฯ ระยอง เชียงใหม่ โคราช หนองคาย สุราษฎร์ฯ ภูเก็ต สงขลา) ติดต่อ 091 774 4329″
Asia Drug & Chemical Ltd. Part.
Asia Drug & Chemical was founded in 1967 as a family-run distributor of raw materials to serve manufacturers. Originally founded as a pharmaceutical trading company, over the years, we have expanded into nutraceutical, food, and beverage operations. We currently represent over 40 global suppliers and serve customers in a wide range of industries. Since our inception, our mission of maintaining exceptional relationships with our suppliers and customers have enabled us to continue to grow alongside our partners. As we grow, our core values and dedication to our partners remains the same as our inception. Throughout the years, we have added more products and established our reputation as one of the leading importer and distributor of ingredients for pharmaceutical, nutraceutical, food & beverage in Thailand. We look forward to nurturing and fostering our relationships as well as our commitments to current and future partners. As we continue to grow, we are seeking candidates who share this vision with us.
Cargill Central Laboratory Cargill Meats (Thailand) Limited
The laboratory dedicated to testing and analyzing complete circuits in the animal and food sectors is accredited to ISO/IEC 17025 by the Bureau of Laboratory Quality Standards (BLQS) DMSc and registered with the National Bureau of Agricultural Commodity and Food Standards (ACFS), DLD, DIW.We utilize modern equipment and employ expert scientists who specialize in their respective fields. Our services are delivered with accuracy and efficiency, ensuring prompt results.
ศูนย์ปฏิบัติการทางวิทยาศาสตร์กลาง บริษัท คาร์กิลล์มีทส์ (ไทยแลนด์) จำกัด
ห้องปฏิบัติการทดสอบและตรวจวิเคราะห์ครบวงจรสำหรับวงการปศุสัตว์ และอุตสาหกรรมอาหาร ได้รับการรับรองมาตรฐาน ISO/IEC17025 จากสํานักมาตรฐานห้องปฏิบัติการกรมวิทยาศาสตร์การแพทย์(BLQS) DMSc และได้รับการขึ้นทะเบียนจาก สํานักงานมาตรฐานสินค้าเกษตรและอาหารแห่งชาติ กรมปศุสัตว์ และกรมโรงงานอุตสาหกรรม ให้บริการทดสอบด้วยอุปกรณ์ เครื่องมือที่ทันสมัย และนักวิทยาศาสตร์ที่มีความเชี่ยวชาญเฉพาะทางให้บริการอย่างถูกต้อง แม่นยำ มีความน่าเชื่อถือในระยะเวลาที่รวดเร็ว
Durasafe Co., Ltd.
Emsland Asia Food Application Co., Ltd.
The Emsland Group is one of the leading companies in creating innovative product solutions based on natural raw materials, potatoes and peas, with healthy properties that are processed into innovative products. We have our own Food Innovation Center in Germany where we can develop products for our customers. We provide native-modified starches, protein, fibres as well as potato flakes and granules. Our products can be used in food industry such as Confectionery, Dairy, Potato products, Pasta and noodles, Soups and sauces, Snacks, Coatings, Bakery and fillings, meat and poultry, fish, and seafood.
บริษัท เอมส์แลนด์ เอเชีย ฟู้ด แอปพลิเคชั่น จำกัด
บริษัท เอมส์แลนด์ กรุ๊ป จำกัด คือหนึ่งในผู้นำด้านการสร้างสรรค์โซลูชันที่มีวัตถุดิบมาจากธรรมชาติ ได้แก่ มันฝรั่งและถั่ว พร้อมทั้งมีคุณสมบัติที่ดีต่อสุขภาพ นอกจากนี้เรามีศูนย์นวัตกรรมทางอาหารในประเทศเยอรมนี ซึ่งเป็นศูนย์ที่ใช้เพื่อการพัฒนาผลิตภัณฑ์ให้แก่ลูกค้าของเรา โดยผลิตภัณฑ์ของเราประกอบไปด้วย แป้งดัดแปร โปรตีน และใยอาหาร รวมถึงผลิตภัณฑ์รูปทรงเม็ดและเกล็ดจากมันฝรั่ง ซึ่งผลิตภัณฑ์ของเราสามารถนำไปใช้ได้ในหลากหลายอุตสาหกรรมอาหาร ตัวอย่างเช่น อุตสาหกรรมขนมหวาน นม ผลิตภัณฑ์จากมันฝรั่ง พาสตาและเส้นก๊วยเตี๋ยว ซุปและซอสชนิดต่างๆ ขนมกรุบกรอบ ผลิตภัณฑ์เคลือบอาหาร เบเกอรีและไส้ขนม เนื้อสัตว์ชนิดต่างๆ รวมถึงอาหารทะเลอีกด้วย
ENEOS (Thailand) Ltd.
ENEOS strives to be one of the leading lubricants suppliers to customers who demand higher productivity and increase the service life of machines and tools in various industrial plants. With our experience and expertise in the oil industry, including our Japanese quality products that are carefully selected, we are prepared to provide our services to meet our customer’s need for high-performance lubrication products and solutions.
บริษัท เอเนออส (ประเทศไทย) จำกัด
ENEOS คือตราสินค้าและบริการสำหรับผลิตภัณฑ์น้ำมันและน้ำมันหล่อลื่นระดับพรีเมียม ที่มียอดขายเป็นอันดับ 1 ในประเทศญี่ปุ่น โดยมีสถานีเชื้อเพลิง ENEOS กว่า 13,000 แห่ง โรงกลั่น 11 แห่ง และมีส่วนแบ่งการตลาดมากกว่า 50% ในประเทศญี่ปุ่น ENEOS ผลิตน้ำมันหล่อลื่นอุตสาหกรรม น้ำมันหล่อลื่นเครื่องจักรกลสำหรับโรงงานผลิตอาหารผ่านการรองรับ HACCP และมีมาตรฐาน NSF จากสหรัฐอเมริกา
Food Innovations and Development Co., Ltd.
Our company goal is to provide customer solution and lso a turn key solution for Food Processing system and also Non Food processing system including Primary and Secondary Packing machine. Also ASRS Warehouse system including AGV and LGV for our customer warehouse
บริษัท ฟู้ดอินโนเวชั่นแอนด์เดเวลอปเม้นท์ จำกัด
เป้าหมายของบริษัทของเราคือการจัดหาแนวทางสำหรับลูกค้าในการแปรรูปสินค้าและบริการในระบบออโตเมชั่น สำหรับสินค้าที่เป็นอาหาร และสินค้าอุปโภคอื่นๆที่ไม่ใช่อาหาร และเครื่องบรรจุหลักและรอง ทั้งนี้ทางบริษัทยังมีระบบ ASRS Warehouse รวมถึง AGV และ LGV สำหรับคลังสินค้าลูกค้า
Fukushima Galilei (Thailand) Co.Ltd.
Sale Commercial Refrigerator / Freezer for food business, Supermarket Showcase and Medical Refrigerator Service and Maintenance Commercial Refrigerator, Kitchen Equipment and Cold Room Design and Installation Restaurant Kitchen, Supermarket and Cold Room
บริษัท ฟุคุชิมะ กาลิเล (ประเทศไทย) จำกัด
จำหน่าย ตู้แช่เย็น ตู้แช่แข็ง สำหรับธุรกิจอาหาร ตู้โชว์เคสสำหรับซุปเปอร์มาร์เก็ต ตู้แช่ทางการแพทย์ รับซ่อมตู้แช่ งานครัวร้านอาหาร ห้องเย็น และออกแบบติดตั้ง งานครัวร้านอาหาร ซุปเปอร์มาร์เก็ต ห้องเย็น
HEALTH INNOTECH Co., Ltd.
Health Innotech Co., Ltd. aims to develop innovative food and healthy functional ingredients. We create added value to agricultural produce to achieve international quality, combining innovation and natural values to offer another sustainable choice for health. Our pioneer product is ‘V-FOS’ (Fructo-Oligosaccharide)– prebiotics that serve as a substrate for microflora in the large intestine to increase the overall intestinal tract health. This is commercially distributed under the trademark “VALLEX”.
บริษัท เฮลท์อินโนเทค จำกัด
บริษัท เฮลท์อินโนเทค จำกัด มุ่งเน้นการพัฒนานวัตกรรมการผลิตอาหาร และ Functional Ingredients เพื่อสุขภาพ โดยริเริ่มและพัฒนาต่อยอดจากผลิตภัณฑ์ทางการเกษตร สู่การเพิ่มมูลค่าและคุณภาพในระดับสากล นับเป็นการผสานนวัตกรรมและคุณค่าจากธรรมชาติ เพื่อเป็นอีกหนึ่งในทางเลือกให้กับผู้บริโภค โดยผลิตภัณฑ์แรกที่ออกสู่ตลาด คือ V-FOS (Fructo-Oligosaccharide) ที่มีคุณสมบัติเป็น Prebiotics ซึ่งทำหน้าที่เป็นอาหารของจุลินทรีย์ที่ดีในลำไส้ใหญ่ โดยดำเนินงานภายใต้แบรนด์ VALLEX (วาลเล็กซ์)
HITEC Food Equipment Co., Ltd.
Supply the world highest -level machinery which provides rich and varied food for people all over the world.
Contribute to develop food culture in the world by providing safe, high-quality, and performance products and by satisfying customer needs with the highest quality service.
Build firm relationships with our important suppliers and support their sales channel expansion.
Encourage all employees to accomplish tasks with creativity, originality, and passion.
บริษัท ไฮเทค ฟู๊ด อีควิปเมนท์ จำกัด
จำหน่ายเครื่องจักรระดับโลกสูงสุด เพื่อคุณภาพอาหารอันสูงสุด และหลากหลายที่สุด สำหรับประชากรในโลกนี้ให้การสนับสนุนและส่งเสริมการพัฒนาวัฒนธรรมอาหาร ด้วยความปลอดภัย มีคุณภาพและประสิทธิภาพสูง ประกอบกับสร้างความพึงพอใจให้ลูกค้าอย่างสูงสุดด้วยการบริการหลังการขายที่มีคุณภาพสูงสุด ให้ความสำคัญกับผู้ผลิตเครื่องจักรและพันธมิตรทางการค้า ด้วยการสร้างความสัมพันธ์ทางธุรกิจที่ยั่งยืนและสนับสนุนเพื่อการขยายช่องทางการค้า ส่งเสริมแนวคิด และเปิดโอกาสให้แสดงความคิดเห็นอย่างเปิดกว้างภายในองค์กร เพื่อก่อให้เกิดการพัฒนาความคิดสร้างสรรค์ ความคิดริเริ่ม และแรงบันดาลใจ
Hoshizaki (Thailand) Limited
Hoshizaki (Thailand) Limited was established in February 2015, providing Service and Hoshizaki products such as commercial ice machines, refrigerators and freezers, sushi cases, etc. for professional kitchen use in Thailand. It is Hoshizaki Thailand’s mission for serving to the foodservice community in Thailand with our quality products and professional services through dealers who have been trained directly by the company.
บริษัท โฮชิซากิ (ประเทศไทย) จำกัด
บริษัท โฮชิซากิ ประเทศไทย จำกัดได้ก่อตั้งเมื่อเดือนกุมภาพันธ์ ปี 2558 ให้บริการและจำหน่ายผลิตภันฑ์ของ โฮชิซากิ เช่น เครื่องผลิตน้ำแข็ง เครื่องทำความเย็น เครื่องแช่แข็ง เครื่องทำความเย็นสำหรับชูชิ เพื่อใช้งานในครัวที่ได้มาตรฐานระดับสากล เป้าหมายหลักของบริษัทคือ การจำหน่ายและให้บริการกับผู้ประกอบการด้านร้านอาหาร ร้านกาแฟ และโรงแรม ในประเทศไทย ด้วยสินค้าที่มีคุณภาพและบริการอย่างมืออาชีพ โดยผ่านตัวแทนจำหน่ายที่ได้รับการฝึกอบรมทางบริษัทโดยตรง
Hygiena International Ltd.
Hygiena™ delivers rapid microbial detection, monitoring, and identification solutions to a wide range of industries, including food and beverage, health care, hospitality, pharmaceuticals, and personal care. Utilizing advanced technologies and patented designs, Hygiena™ provides industry-leading ATP monitoring systems, PCR-based foodborne pathogen detection, DNA fingerprint molecular characterization systems, allergen tests, environmental collection devices, and more. Hygiena™ is committed to providing customers with high-quality innovative technologies that are easy-to-use and reliable, backed by excellent customer service and support.
Hygiena™ นำวิธีการตรวจหาจุลินทรีย์ การเฝ้าติดตามและการวินิจฉัยเชื้อจุลินทรีย์อย่างรวดเร็วมาสู่วงการต่างๆ อย่างกว้างขวาง ทั้งอุตสาหกรรมอาหารและเครื่องดื่ม การดูแลสุขภาพ แผนกต้อนรับ งานเภสัชกรรม และอนามัยส่วนบุคคล ผลิตภัณฑ์ของ Hygiena™ ใช้เทคโนโลยีขั้นสูงและได้รับการจดสิทธิบัตรแล้ว ไม่ว่าจะเป็น ระบบตรวจวัด ATP ที่เป็นผู้นำของวงการ การตรวจหาเชื้อก่อโรคในอาหารโดยเทคนิค PCR ระบบการจำแนกลักษณะของ DNA ในระดับโมเลกุล การทดสอบสารก่อภูมิแพ้ อุปกรณ์สำหรับเก็บตัวอย่างจากสิ่งแวดล้อมและอื่นๆ Hygiena™ มุ่งมั่นที่จะให้บริการลูกค้าด้วยนวัตกรรมเทคโนโลยีคุณภาพสูงที่ใช้งานง่ายและเชื่อถือได้ โดยมีทีมงานที่คอยให้การบริการและสนับสนุนลูกค้าที่ยอดเยี่ยม
IMCD (Thailand) Co., Ltd.
We are experts in the distribution of specialty food ingredients and flavours from the world’s leading manufacturers. As your partner, we are committed to solving your formulation challenges and creating healthy, convenient, and sustainable solutions that are consumer trend-led and exceed all expectations
บริษัท ไอเอ็มซีดี (ไทยแลนด์) จำกัด
เราเป็นผู้เชี่ยวชาญในการจัดจำหน่ายส่วนผสมและรสชาติอาหารพิเศษจากผู้ผลิตชั้นนำของโลก ในฐานะพันธมิตรของคุณเรามุ่งมั่นที่จะแก้ปัญหาความท้าทายในการกำหนดสูตรของคุณและสร้างโซลูชันที่ดีต่อสุขภาพสะดวกและยั่งยืนซึ่งเป็นผู้นำเทรนด์ของผู้บริโภคและเหนือความคาดหมายทั้งหมด
Infor Software (Thailand) Limited
ITS (Thailand) Co., Ltd.
ITS Thailand provides total solution for fully integrated laboratory setup. This includes laboratory design and build, and providing workflow solutions via our comprehensive range of scientific instruments. ITS Thailand has a dedicated team of sales and service engineers fully capable of providing a comprehensive range of services from application, installation, commissioning, to repair. The company also ensures the optimization of product performance via the Preventive Maintenance Program catered to suit customers’ needs. ITS Thailand integrates its resources in multiple countries to give a single point of contact facilitating turnkey project management, marketing management, business coordination management, as well as logistics & service engineering management for the entire region.
บริษัท ไอทีเอส (ไทยแลนด์) จำกัด
ITS Thailand นำเสนอโซลูชั่นที่ครบวงจรสำหรับการติดตั้งห้องปฏิบัติการแบบครบวงจร ซึ่งรวมถึงการออกแบบและสร้างห้องปฏิบัติการและการจัดหาโซลูชันเวิร์กโฟลว์ผ่านเครื่องมือทางวิทยาศาสตร์ที่ครอบคลุมของเรา ITS Thailand มีทีมวิศวกรฝ่ายขายและฝ่ายบริการโดยเฉพาะซึ่งสามารถให้บริการได้อย่างครอบคลุมตั้งแต่ การติดตั้ง, การว่าจ้างและการซ่อมแซม นอกจากนี้ บริษัท ยังรับประกันการเพิ่มประสิทธิภาพของผลิตภัณฑ์ผ่านโปรแกรมการบำรุงรักษาเชิงป้องกันที่รองรับความต้องการของลูกค้า ITS Thailand ผสานรวมทรัพยากรในหลายประเทศเพื่อให้เป็นจุดติดต่อจุดเดียวที่อำนวยความสะดวกในการจัดการโครงการแบบครบวงจรการจัดการการตลาดการจัดการการประสานงานทางธุรกิจตลอดจนการจัดการวิศวกรรมโลจิสติกส์และบริการสำหรับทั้งภูมิภาค
Mayekawa (Thailand) Co., Ltd.
Mayekawa (Thailand)=MTH was established in September 1988 to promote sales of MYCOM compressor, supports plant design and construction for refrigeration facilities and also local manufacturing of freezers for cooling and freezing food. MTH has designed and installation of equipment includeing automated deboning machines and automated transfer system, etc.
บริษัท มาเยคาว่า (ประเทศไทย) จำกัด
Mayekawa (Thailand) = MTH ก่อตั้งขึ้นในเดือนกันยายน พ.ศ. 2531 เพื่อส่งเสริมการขายคอมเพรสเซอร์แบรนด์ MYCOM สนับสนุนการออกแบบและติดตั้งระบบทำความเย็นในโรงงาน ทำการผลิตตู้แช่แข็งสำหรับการลดอุณหภูมิและการแช่แข็งอาหาร การออกแบบและติดตั้งอุปกรณ์ซึ่งรวมถึงเครื่องเลาะกระดูกไก่แบบอัตโนมัติและระบบสายพานลำเลียงอัตโนมัติด้วย
Mettler-Toledo (Thailand) Limited
METTLER TOLEDO is a manufacturer and provider of analytical instruments. Laboratory balance and industrial scales with high precision at the top of the world.
We offer solutions for laboratory analytical instruments, inline analytical instruments, digital balances. And product inspection machines that can be used in every production process of the customer.
To help make every process of the customer the most efficient Improves productivity Reduces operating costs and meets current regulations.
บริษัท เมทเล่อร์-โทเลโด (ประเทศไทย) จำกัด
METTLER TOLEDO เป็นผู้ผลิตและผู้ให้บริการเครื่องมือวิเคราะห์ เครื่องชั่งในห้องปฏิบัติการ และเครื่องชั่งในอุตสาหกรรมที่มีความแม่นยำสูงในระดับต้นๆ ของโลก เรานำเสนอโซลูชันเครื่องมือวิเคราะห์ในห้องปฏิบัติการ, เครื่องมือวิเคราะห์แบบอินไลน์, เครื่องชั่งดิจิทัล และเครื่องตรวจสอบผลิตภัณฑ์ที่ตอบโจทย์การใช้งานได้ครบทุกกระบวนการผลิตของลูกค้า เพื่อช่วยให้ทุกกระบวนการของลูกค้ามีประสิทธิภาพสูงสุด ช่วยเพิ่มผลผลิต ลดต้นทุนในการดำเนินงานและเป็นไปตามกฏข้อกำหนดในปัจจุบัน
MT Food Systems Co., Ltd.
This Company focuses on new high technologies and solutions for improving productivity and increasing yield in food processing plant which is specific on poultry, pork, seafood and liquid food. We specialize in providing unique solutions for the meat preparation, cutting, slicing, grading, cooking and packing. We make it a priority to build and maintain partnerships, to build and deliver solutions to our customers. We understand that business relations are the foundation of success, and that’s why our priority is to build strong lasting relations with our customers. We see our clients’ business as ours, and we work continuously on bettering partnerships, to be able to provide the optimum know-how and services to our customers Trust, Innovation, Quality and our Service team are the values upon which we built our growth and success, and which we live and work by.
บริษัท เอ็มที ฟู้ด ซิสเต็มส์ จำกัด
บริษัท นี้มุ่งเน้นไปที่เทคโนโลยีขั้นสูงและโซลูชั่นใหม่ ๆ เพื่อเพิ่มผลผลิตและเพิ่มผลผลิตในโรงงานแปรรูปอาหารสำหรับสัตว์ปีกเนื้อหมูอาหารทะเลและอาหารเหลว เรามีความเชี่ยวชาญในการนำเสนอโซลูชั่นเฉพาะสำหรับการเตรียมเนื้อการหั่นการหั่นการคัดเกรดการปรุงอาหารและการบรรจุหีบห่อ เราให้ความสำคัญในการสร้างและรักษาความเป็นหุ้นส่วนสร้างและส่งมอบโซลูชันให้กับลูกค้าของเรา เราเข้าใจดีว่าความสัมพันธ์ทางธุรกิจเป็นรากฐานของความสำเร็จและนั่นคือเหตุผลที่เราให้ความสำคัญกับการสร้างความสัมพันธ์ที่แน่นแฟ้นกับลูกค้าของเรา เรามองว่าธุรกิจของลูกค้าเป็นของเราและเราทำงานอย่างต่อเนื่องในการพัฒนาความร่วมมือที่ดีขึ้นเพื่อให้สามารถมอบความรู้และบริการที่ดีที่สุดแก่ลูกค้าของเราความไว้วางใจนวัตกรรมคุณภาพและทีมบริการของเรา
Multitech Foods Manufacturing Co., Ltd.
MTF is the leading company in Thailand to produce powder form products from Spray Dry technology. We select advanced technology in the production line to produce high quality products that can be used in various food industry to resemble its natural uniqueness
บริษัท มัลติเทค ฟู้ด แมนูแฟคเจอริ่ง จำกัด
ผู้นำด้านการแปรรูปสินค้าจากวัตถุดิบธรรมชาติ ให้อยู่ในรูปแบบผง บริษัทได้คัดสรรนวัตกรรมและเทคโนโลยีที่ทันสมัยมาใช้ในกระบวนการผลิต เพื่อสร้างสรรค์ผลิตภัณฑ์ที่มีความโดดเด่นทั้งในด้านคุณภาพ และคุณสมบัติของผลิตภัณฑ์ ที่สามารถนำไปใช้เป็นสารเติมแต่งรสชาติ และกลิ่นให้แก่อาหารได้เป็นอย่างดี
Multivac Co., Ltd.
MULTIVAC is one of the leading providers worldwide of packaging solutions for food products of all types, life science and healthcare products and industrial items.
The MULTIVAC product portfolio comprises a wide range of packaging technologies, labelling and marking equipment, quality control systems, and automation solutions. Our product range is completed with equipment upstream of the packaging machine in the areas of portioning and processing of food – especially meat and bakery products.
บริษัท มัลติแว็ค จำกัด
MULTIVAC เป็นหนึ่งในผู้นำของโลกที่ให้บริการด้านแพ็คเก็จจิ้งสำหรับผลิตภัณฑ์กลุ่มอาหาร กลุ่มดูแลสุขภาพ และกลุ่มอุตสาหกรรมสินค้าของ MULTIVAC ประกอบด้วยอุปกรณ์ที่มีความหลากหลายในเทคโนโลยีด้านแพ็คเก็จจิ้ง ด้านฉลากตราสินค้า ด้านระบบการควบคุม ด้านโซลูชั่นออโตเมชั่น ด้านการหั่นและแบ่งสัดส่วนเนื้อ รวมถึงอุปกรณ์สำหรับสินค้าในกลุ่มเบเกอรี่
Nufitech Group Co., Ltd.
Nufitech Group Co., Ltd is importer and distributor of food ingredients supplying to all sections of food manufacturers. We provide food ingredients for dietary supplement and also functional food and drinks such as plant&animal extracts, probiotic, fibers, amino acids, vitamins, caramel colours, fruit&vegetable powders, teas, cereals and more.
บริษัท นิวฟีเทค กรุ๊ป จำกัด
ผู้นำเข้าและตัวแทนจำหน่ายวัตถุดิบ ส่วนประกอบอาหารสำหรับกลุ่มลูกค้าโรงงานอุตสาหกรรมอาหารทุกขนาด เราจัดจำหน่ายวัตถุดิบสำหรับผลิตภัณฑ์เสริมอาหาร รวมถึงกลุ่มอาหารและเครื่องดื่มเพื่อสุขภาพ เช่น สารสกัดจากพืชและสัตว์ โพรไบโอติก ไฟเบอร์ กรดอะมิโน วิตามิน สีคาราเมล ผักและผลไม้ผง ชา ธัญพืช และอื่นๆอีกมากมาย
Official Equipment Manufacturing Co., Ltd.
Whether you are planning a new laboratory building or extension, redesigning or replacing laboratory furniture and equipment, you just call as OFFICIAL We have our own planners, designers and technical specialists by our team more over 200 persons. Service local and ASEAN network countries.
บริษัท ออฟฟิเชียล อีควิปเม้นท์ แมนูแฟคเจอริ่ง จำกัด
ผู้ผลิตและจัดจำหน่าย เฟอร์นิเจอร์ ห้องทดลองวิทยาศาสตร์ ออกแบบ ห้องแลป ตู้ดูดควัน ตู้ดูดควันไอสารพิษ ตู้เหล็กเก็บของ ชั้นเหล็กวาง ของอเนกประสงค์ และโต๊ะสำหรับช่างซ่อมบำรุง ด้วยกระบวนการผลิต ที่ทันสมัย และพ่นด้วยสีผงอุตสาหกรรม ทำให้ชุดเฟอร์นิเจอร์เหล็กของ Leader มีความคงทน แข็งแรง และสวยงาม ผลิตภัณฑ์ทุกชิ้นที่ผลิตจากโรงงานได้รับมาตรฐานการรับรอง ISO 9001:2015 และ ISO 14001
Ohaus Indochina Limited
OHAUS INDOCHINA Ltd., we are main authorized distributor of Laboratory Balance and Industrial Scale, furthermore Basic Laboratory Equipment such as Vortex Mixer, pH meter, Centrifuge, Hotplate Stirrer and so on under US brand “OHAUS”.
บริษัท โอเฮ้าส์ อินโดไชน่า จำกัด
บริษัท โอเฮ้าส์ อินโดไชน่า จำกัด จัดจำหน่ายเครื่องชั่งสำหรับห้องปฏิบัติการ รวมทั้งเครื่องชั่งที่ใช้ในกระบวนการผลิต นอกจากนี้ยังมีเครื่องมือวิทยาศาสตร์พื้นฐานเช่นเครื่องเขย่า เครื่องวัดความเป็นกรด-ด่าง เครื่องปั่นเหวี่ยง เครื่องกวนสารละลายแบบให้ความร้อนและอีกหลายประเภทภายใต้แบรนด์ “OHAUS” ประเทศสหรัฐอเมริกา
PRG Global Co., Ltd. “Who says you cannot eat sweet and being healthy at the same time??!!!
Our Sucrost is the Sweetener Solution invented to replace sugar and its tasting profile is 95% similar to sugar, without any aftertaste. Due to its low-calorie amount, Sucrost is highly suitable for sugar reduction diets and diabetics.
At the same time, Sucrost is easy to use in production which requires only minor to none adjustment. The sweetness intensity range is from 10 times to 300 times at a lower price than sugar.”
บริษัท พี อาร์ จี โกลบอล จำกัด
“SUCROST เป็นสารให้ความหวานทดแทนน้ำตาล ที่มีคุณสมบัติทางกายภาพใกล้เคียงกับน้ำตาลกว่า 95% ซึ่งมากกว่าสารให้ความหวานหลักชนิดอื่นๆ โดยไม่ทิ้งรสขมไว้หลังรับประทาน มีแคลอรี่ต่ำ เหมาะสำหรับผู้ที่ควบคุมน้ำตาล หรือผู้เป็นเบาหวาน
SUCROST จึงง่ายต่อการพัฒนา/ปรับสูตรกับสินค้าที่ใช้น้ำตาลอยู่แล้ว โดยไม่จำเป็นต้องใช้สารให้ความหวานอื่นๆ ช่วยในการปรับรสชาติ อาจกล่าวได้ว่าสามารถลดการใช้น้ำตาลในสูตรการผลิตลงได้ถึง 97% โดยมีระดับความหวานให้เลือกตั้งแต่ 10 เท่าจนถึง 300 เท่าของน้ำตาลปกติ”
Pure Chemicals Co., Ltd.
“Pure chemicals Company Limited was established in 1973. We were recognized as a leading company in Thailand, representing world-class manufacturers of food and functional ingredient covering food, food supplement, beverage, dairy, bakery, confectionery, pet food and feed industry.
Our philosophy is to add more value for our partners and customers. We have invested in the innovation center to provide the formulation and solution for our valued customers. With our experience and strong technical sales and specialist team, we work as consultants who find the best solution and create a new concept for our valued customers. Our passion is to help them expand their business and grow together in the future.”
บริษัท เพียวเคมีกัลส์ จำกัด
ด้วยประสบการณ์ยาวนานมากกว่า 50 ปี ในอุตสากรรมเคมีอาหาร ปัจจุบันบริษัท เพียวเคมีกัลส์ จำกัด ยังคงพัฒนาธุรกิจอย่างต่อเนื่อง เพื่อนำเสนอวัตถุดิบที่มีคุณภาพจากทั่วโลกให้แก่คู่ค้าในอุตสากรรมอาหารหลายชนิด เช่น เครื่องดื่ม ผลิตภัณฑ์นม เบเกอรี ขนมหวาน ผลิตภัณฑ์อาหารเสริม รวมถึงอุตสาหกรรมอาหารสัตว์อีกด้วย พันธกิจหลักของบริษัทฯ คือ การเป็นพันธมิตรทางธุรกิจกับคู่ค้าและลูกค้าของเราในระยะยาว พร้อมให้คำปรึกษาและทำงานอย่างใกล้ชิดกับคู่ค้า โดยสามารถสร้างสรรค์สูตรสินค้าที่ตรงตามความต้องการของธุรกิจ ทั้งยังเป็นผู้นำในการสร้างสินค้าและนวัตกรรมให้เกิดขึ้นในวงการอาหารและสุขภาพของประเทศไทย เรามีความยินดีเป็นอย่างยิ่งที่ได้มีส่วนร่วมในการพัฒนาสินค้าที่มีคุณภาพและมีคุณประโยชน์ต่อผู้บริโภคในประเทศไทย โดยยึดหลักการบริหารด้วยธรรมาภิบาล ความซื่อสัตย์ และ บริการอย่างเต็มความสามารรถ ทั้งนี้เรามุ่งมั่นอย่างเต็มที่ในการทำงานเพื่อความสำเร็จของคู่ค้าและลูกค้าทุกท่าน ดังปรัชญาของเรา “เพียวเคมีกัลส์ พันธมิตรที่ดีที่สุดของคุณในอุตสาหกรรมวัตถุดิบทางอาหาร
SE Analytiks Co., Ltd.
Our products and solutions. We focus on innovative and differentiated solutions and technologies that add high value to our end-user’s applications and processes. We are committed to operational excellence and innovation that help our customers create the products and services that make better. Our continued strategic and expansion offers significant future opportunities across our value for our channel partners and our suppliers for our customers.
บริษัท เอสอี อนาไลติกส์ จำกัด
บริษัท เอสอี อนาไลติกส์ ได้คัดสรร สินค้าด้วยเทคโนโลยีและมีคุณภาพสูง เพื่อตอบโจทย์ ความต้องการที่หลากหลายของ การเพิ่มประสิทธิภาพ คุณภาพขบวนการผลิตที่สูงขึ้น
Senta Pack Machinery & Service Co., Ltd.
“We are leaders in the quality of modern machine and technology. We have gained trust from more than 500 customers, which include both corporations in food industry and SME food producers.
Moreover, we still have a team of technician with specific expertise, everyone has trained directly from the manufacturer of machine to have know-how and quick solutions. At the same time, we also provide services regarding the spare parts and needed equipment for the machine. Always be on time and efficient service as required by customers for the confidence and satisfaction of customers is the most important.”
บริษัท เซนต้า แพ็ค แมชชีนเนอรี่ แอนด์ เซอร์วิส จำกัด
“เราเป็นผู้นำผู้นำในด้านคุณภาพของเครื่องจักรและเทคโนโลยีที่ทันสมัย ได้รับความไว้วางใจจากลูกค้าทั้งในกลุ่มธุรกิจอุตสาหกรรมอาหารขนาดใหญ่และกลุ่มธุรกิจ SMEs มากกว่า 500 ราย
นอกเหนือจากคุณภาพของเครื่องจักรที่เป็นที่ยอมรับ เรายังมีทีมงานที่มีความเชี่ยวชาญเฉพาะด้านไว้สำหรับบริการหลังการขายให้กับลูกค้าของเราอย่างมีประสิทธิภาพ โดยเจ้าหน้าที่และทีมงานของเราทุกคนได้ผ่านการฝึกอบรมจากโรงงานผู้ผลิตเครื่องจักรโดยตรง อีกทั้งเรายังมีการบริการเกี่ยวกับอะไหล่และอุปกรณ์ ที่จำเป็นสำหรับเครื่องจักร ไว้คอยบริการอย่างทันท่วงทีและมีประสิทธิภาพตามที่ลูกค้าต้องการเพื่อความเชื่อมั่นและความพึงพอใจของลูกค้าเป็นสำคัญ”
Sevenlakes International Co., Ltd.
Develop and supply “Thermoforming Packaging”. With over 14 years of experiences in this field and our professional team, we’re confident in helping our customers develop this type of packaging based on our integrity in selling safe materials for end consumers.
บริษัท เซเว่นเลคส์ อินเตอร์เนชั่นแนล จำกัด
พัฒนาและจำหน่ายฟิล์ม Thermoform ด้วยประสบการณ์กว่า 14 ปีทางด้านฟิล์ม Thermoform นี้โดยเฉพาะพร้อมทีมงานมืออาชีพ บริษัทฯมีความเชื่อมั่นในการช่วยเหลือและดูแลลูกค้าในการพัฒนาบรรจุภัณฑ์ชนิดนี้โดยยึดถือความซื่อสัตย์ในการจำหน่ายฟิล์มที่ปลอดภัยต่อผู้บริโภค
Tetra Pak
ABOUT TETRA PAK
Tetra Pak is a world leading food processing and packaging solutions company. Working closely with our customers and suppliers, we provide safe, innovative and environmentally sound products that each day meet the needs of hundreds of millions of people in more than 160 countries. With more than 25,000 employees around the world, we believe in responsible industry leadership and a sustainable approach to business.
เต็ดตรา แพ้ค
เต็ดตรา แพ้ค คือผู้นำเสนอโซลูชันบรรจุภัณฑ์และกระบวนการผลิตอาหารชั้นนำของโลก โดยทำงานร่วมกับลูกค้าและซัพพลายเออร์อย่างใกล้ชิด เพื่อมอบผลิตภัณฑ์ที่ปลอดภัย ทันสมัย และเป็นมิตรต่อสิ่งแวดล้อมซึ่งตอบสนองความต้องการของผู้คนนับพันล้านในกว่า 160 ประเทศทั่วโลก ด้วยจำนวนพนักงานมากกว่า 25,000 คนซึ่งมีฐานการดำเนินงานทั่วโลก เราเชื่อในความรับผิดชอบของเราในฐานะผู้นำอุตสาหกรรมและการมอบความยั่งยืนแก่ธุรกิจนี้
Thai Udonthani Sugar Mill Co., Ltd.
Thaiflex Equipment Co.,Ltd.
Thaiflex Equipment Co.,ltd is one of leading company who expertise in Centrifugal Technology and Heat Exchanger Technology. We are authorized agent of HAUS Centrifugal Technology. HAUS is Turkish expertise in Centrifugal Technology, they produce Decanter and Separator for many application include Food, Beverage, Chemical and Waste water industry.
This Decanter and Separator is used to separate solid , liquid and Oil from each other.
บริษัทไทยเฟล็กซ์อีควิปเม้นท์จำกัด
เป็นผู้นำและผู้เชี่ยวชาญเรื่องระบบ Centrifugal Technology และ Heat Exchanger Technology. เราเป็นตัวแทนอย่างเป็นทางการของ HAUS Centrifugal Technology. HAUS เป็นผู้เชี่ยวชาญเรื่องเครื่องแยกการสัญชาติตุรกี เขาผลิตเครื่อง Decanter และ Separator ที่ใช้แยกของแข็ง ของเหลว และน้ำมันออกจากกันได้
ULMA Packaging (Thailand) Co., Ltd.
Manufacturer of high-quality packaging machines from Spain. We provide Thermoform, Traysealing, Horizontal Flow wrap and Vertical Form Fill Seal (VFFS) machines. We provide customers with standalone machine till complete turnkey solutions in various food industries.
บริษัท อัลม่า แพ็คเกจจิ้ง (ประเทศไทย) จำกัด
เป็นผู้ผลิตและจัดจำหน่ายเครื่องบรรจุภัณฑ์ที่มีประสิทธิภาพสูง มาพร้อมกับเทคโนโลยีที่ทันสมัยจากประเทศสเปน ซึ่งเรามีบริการทั้ง เครื่อง Thermoforming เครื่อง Traysealing เครื่อง Horizontal Flow Pack และ เครื่อง Vertical Flow Pack (VFFS) และเรายังมีบริการตั้งแต่เครื่องแพ๊คแบบไลน์เดี่ยว ไปจนถึงการติดตั้งแบบครบวงจรของกระบวนการการผลิตทั้งหมด เพื่อเป็นทางเลือกและตอบสนองต่อความต้องการของลูกค้าในวงการอุตสาหกรรมอาหารต่างๆ ให้ได้มากที่สุด
VEGA Instruments Co., Ltd.
VEGA is a global manufacturer of sensors for measuring level, point level, pressure as well as devices and software for integrating them into process control systems. Solutions for a wide variety of industries.
Every industry has its own specific requirements for the measurement technology. VEGA sensors reliably solve the most difficult measurement problems worldwide. Any common adapter system that complies with EC 1935/2004, FDA, EHEDG, 3-A can be used for level sensors as well as for pressure and point level sensors. Whether all metallic or with elastomer O-ring sealing: The sensors fit all standard, commercially available hygienic connections.
บริษัท วีก้า อินสตรูเมนท์ จำกัด
VEGA เป็นผู้ผลิตเซนเซอร์ระดับโลก โดยอุปกรณ์เซนเซอร์ได้ถูกนำไปใช้ในงานวัดระดับของเหลวและของแข็งทุกประเภท รวมไปถึงเซนเซอร์ที่ใช้ในงานวัดแรงดัน ตลอดจนอุปกรณ์และซอฟต์แวร์ที่ใช้ในระบบควบคุมการผลิตสำหรับหลากหลายอุตสาหกรรม
ทุกอุตสาหกรรมมีข้อกำหนดในเรื่องเทคโนโลยีการวัดที่เฉพาะตัว เซนเซอร์จาก VEGA สามารถช่วยแก้ปัญหาในกระบวนการวัดที่มีความซับซ้อนได้อย่างมีประสิทธิภาพ ระบบอะแดปเตอร์ทั่วไปที่เป็นไปตามมาตรฐสากล เช่น EC 1935/2004 FDA EHEDG และ 3-A สามารถนำมาใช้กับเซนเซอร์วัดระดับและแรงดันของ VEGA ไม่ว่าจะผลิตจากโลหะทั้งชิ้นหรือปิดผนึกโอริงแบบอีลาสโตเมอร์ก็ตาม เซนเซอร์จาก VEGA ตอบโจทย์มาตรฐานต่างๆ และถูกสุขอนามัยอย่างแน่นอนระดับโลก
Yamamori Trading Co., Ltd.
We specialize in researching, developing, and producing Japanese soy sauce, soy sauce-based seasoning sauce, retort pouch food and so on. Our mission is to enhance the philosophy of producing food “Taking a time preciously on each product,” as it is the fundamental factor of brewing. “Picturing a never-ending dream and pursuit the satisfaction of customers”. We keep challenging as a global food maker.
บริษัท ยามาโมริ เทรดดิ้ง จำกัด
เราเป็นผู้เชี่ยวชาญในการวิจัย พัฒนา ไปจนถึงการผลิตซอสถั่วเหลืองญี่ปุ่น ซอสปรุงรสสไตล์ญี่ปุ่น อาหารพร้อมทานบรรจุถุง เรามีพันธกิจในการเสริมสร้างการผลิตอาหาร ภายใต้ปรัชญา “Taking a time preciously on each product” ดังที่เวลาเป็นปัจจัยพื้นฐานในกระบวนการหมัก “Picturing a never-ending dream and pursuit the satisfaction of customers” คงความท้าทายในฐานะผู้ผลิตอาหารระดับโลก”